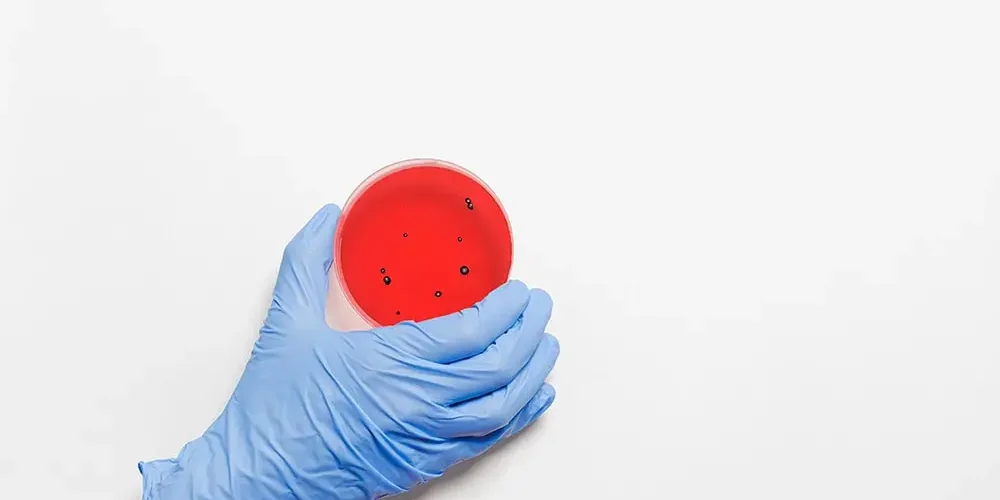
The hand of a doctor in a blue glove holds a container with bacterial flora

Blog for Patients

In vitro fertilization
Everything You Need To Know About In Vitro Fertilization. Not every woman can get pregnant easily. Sometimes you have to really flex, a lot...
Bacterial flora
Maintaining the appropriate bacterial flora in the body is extremely important to ensure the proper functioning of the human body. Over 1,000 different types of bacteria..

COVID 19 vaccine
Vaccine - the most important information
COVID-19 is an infectious disease caused by a new coronavirus called SARS-CoV-2. This virus is most likely a mutation of other viruses

Have you defeated COVID-19? Give back the plasma!
Have you been sick with the coronavirus and have recovered? Donate your plasma and help others heal!
Your plasma contains antibodies that can help treat COVID-19..

Is it really sciatica?
Sciatica - How To Recognize And Treat It? The pear-shaped muscle is the structure located in the gluteal area responsible for external rotation, abduction...

Control tests – at what age, what to test
Control tests are aimed at checking our health. We should perform them regularly in order to quickly detect possible irregularities and the beginning of serious diseases...

West Nile virus – symptoms, causes, treatment
West Nile virus in Poland? The fact that we live in Poland does not mean that we will not get infected with diseases that come

Czy opalanie w solarium jest bezpieczne?
Every woman dreams of a beautiful skin and complexion, which is undoubtedly the result of a tan. Now, when we have access to a solarium, we can...

